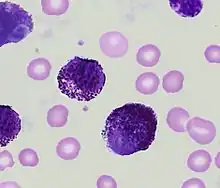

| Acute mast cell leukemia | |
|---|---|
![]() | |
| Peripheral blood showing mast cell leukemia. | |
| Specialty | Hematology and oncology |
Mast cell leukemia is an extremely aggressive subtype of acute myeloid leukemia that usually occurs de novo but can, rarely, evolve from transformation of chronic myeloid leukemia into the more aggressive acute myeloid leukemia. In a small proportion of cases, acute mast cell leukemia may evolve from a more progressive form of systemic mastocytosis. The diagnosis of acute mast cell leukemia by the WHO criteria includes the requirement for a prevalence of 20% neoplastic mast cells in marrow and 10% in blood.[1] If the mast cells represent less than 10% of blood cells, the tumor is called "aleukemic" mast cell leukemia.
Signs and symptoms
Acute mast cell leukemia is a rapidly progressive disorder with leukemic mast cells in blood and in large numbers in marrow. The common signs and symptoms include fever, headache, flushing of face and trunk.[2][3] The typical cutaneous mast cell infiltrates of urticaria pigmentosa are usually not present before, during, or after diagnosis in patients who have mast cell leukemia.[4] Symptoms include abdominal pain, bone pain, and peptic ulcer which are more prevalent than in other subtypes of acute myeloid leukemia. These former symptoms are due to release of a substance called histamine from neoplastic mast cells.[5] Enlargement of the liver and spleen, or hepatosplenomegaly is characteristic.[6] The mast cells release also many anticoagulants like heparin which can lead to serious bleeding. Liver and splenic dysfunction also contributes to hemorrhage.[7] Involvement of the bone can lead to osteoporosis. Abdominal ultrasound or computerized tomography (CT) scanning is used to look for hepatosplenomegaly and lymphadenopathy. Plain radiography and bone densitometry can be used to assess bone involvement and the presence of osteoporosis. Endoscopy and biopsy can be useful if gut involvement is suspected.[8]
Diagnosis
Cytochemistry
Cytochemical properties of the leukemic cells must be typical of mast cell derivation (presence of metachromatic granules staining with alpha-naphthyl chloroacetate esterase, but not with peroxidase).[6] Mast cell tryptase is an enzyme contained in mast cell granules. Mast cell numbers are best estimated by tryptase immunostaining because very poorly granulated cells may stain very weakly if at all for alpha-naphthol chloroacetate esterase.[1]
Tumor markers
The leukemic cells usually are strongly positive for CD13, CD33, CD68, and CD117. Characteristically, basophil (e.g. CD11b, CD123) and monocyte markers (CD14, CD15) are absent. The cells usually express CD2 and CD25.[9] Malignant mast cells overexpress the anti-apoptosis gene, bcl-2.[10] A mutation called KIT mutation is detected in most patients.[11]
Biochemistry
Total serum tryptase is elevated in mast cell leukemia. Normal total (alpha + beta) serum tryptase is approximately 6 micro g/L (range 0 to 11 micro g/L). Values of several hundred micro g/L are characteristic of mast cell leukemia.[12] Plasma and urinary histamine levels are frequently elevated in mast cell leukemia. Histidine decarboxylase (HDC) is the enzyme that catalyzes the reaction which produces histamine from histidine. Measurement of histidine carboxylase in the marrow cells of patients with mast cell leukemia is a very sensitive marker of mast cells.[13]
Treatment
Immunoglobulin E (IgE) is important in mast cell function. Immunotherapy with anti-IgE immunoglobulin raised in sheep resulted in a transient decrease in the numbers of circulating mast cells in one patient with mast cell leukemia.[14] Although splenectomy has led to brief responses in patients with mast cell leukemia,[4][15] no firm conclusions as to the efficacy of this treatment are possible. Chemotherapy with combination of cytosine arabinoside and either idarubicin, daunomycin, or mitoxantrone as for acute myeloid leukemia has been used. Stem cell transplantation is an option, although no experience exists concerning responses and outcome.[11]
Prognosis
Acute mast cell leukemia is extremely aggressive and has a grave prognosis. In most cases, multi-organ failure including bone marrow failure develops over weeks to months.[16] Median survival after diagnosis is only about 6 months.[4]
References
- 1 2 Lichtman MA, Segel GB (2005). "Uncommon phenotypes of acute myelogenous leukemia: basophilic, mast cell, eosinophilic, and myeloid dendritic cell subtypes: a review". Blood Cells Mol. Dis. 35 (3): 370–83. doi:10.1016/j.bcmd.2005.08.006. PMID 16203163.
- ↑ Daniel MT, Flandrin G, Bernard J (1975). "[Acute mast-cell leukemia. Cytochemical and ultrastructural study, about a particular case (author's transl)]". Nouv Rev Fr Hematol (in French). 15 (3): 319–32. PMID 54900.
- ↑ Le Cam MT, Wolkenstein P, Cosnes A, et al. (1997). "[Acute mast cell leukemia disclosed by vasomotor flushing]". Ann Dermatol Venereol (in French). 124 (9): 621–2. PMID 9739925.
- 1 2 3 Travis WD, Li CY, Hoagland HC, Travis LB, Banks PM (December 1986). "Mast cell leukemia: report of a case and review of the literature". Mayo Clin. Proc. 61 (12): 957–66. doi:10.1016/s0025-6196(12)62636-6. PMID 3095598.
- ↑ Valent P, Sperr WR, Samorapoompichit P, et al. (July 2001). "Myelomastocytic overlap syndromes: biology, criteria, and relationship to mastocytosis". Leuk. Res. 25 (7): 595–602. doi:10.1016/S0145-2126(01)00040-6. PMID 11377685.
- 1 2 Kufe D, et al. (2000). Holland Frei Cancer Medicine (5th ed.). BC Decker.
- ↑ Cather JC, Menter MA (July 2000). "Red-brown skin lesions and pruritus". Proc (Bayl Univ Med Cent). 13 (3): 297–9. doi:10.1080/08998280.2000.11927693. PMC 1317061. PMID 16389403.
- ↑ Hoffbrand AV, Catovsky D, Tuddenham E (2005). Postgraduate Haematology (5th ed.). Blackwell.
- ↑ Valent P (October 1995). "1995 Mack-Forster Award Lecture. Review. Mast cell differentiation antigens: expression in normal and malignant cells and use for diagnostic purposes". Eur. J. Clin. Invest. 25 (10): 715–20. doi:10.1111/j.1365-2362.1995.tb01948.x. PMID 8557056. S2CID 23872236.
- ↑ Cerveró C, Escribano L, San Miguel JF, et al. (March 1999). "Expression of Bcl-2 by human bone marrow mast cells and its overexpression in mast cell leukemia". Am. J. Hematol. 60 (3): 191–5. doi:10.1002/(SICI)1096-8652(199903)60:3<191::AID-AJH4>3.0.CO;2-Y. PMID 10072109.
- 1 2 Ansell SM, ed. (2008). Rare Hematological Malignancies. Cancer Treatment & Research. Springer.
- ↑ Sperr WR, Jordan JH, Fiegl M, et al. (June 2002). "Serum tryptase levels in patients with mastocytosis: correlation with mast cell burden and implication for defining the category of disease". Int. Arch. Allergy Immunol. 128 (2): 136–41. doi:10.1159/000059404. PMID 12065914. S2CID 42677668.
- ↑ Krauth MT, Agis H, Aichberger KJ, et al. (November 2004), "Histidine carboxylase (HDC) as novel marker of immature neoplastic mast cells in systemic mastocytosis", Blood, Abstracts of the American Society of Hematology 46th Annual Meeting. December 4–7, 2004, San Diego, California, USA, 104 (11 Pt 2): 272b, doi:10.1182/blood.V104.11.4755.4755, PMID 15562525
- ↑ Ribeiro I, Carvalho IR, Fontes M, et al. (July 1993). "Eosinophilic leukaemia with trisomy 8 and double gammopathy". J. Clin. Pathol. 46 (7): 672–3. doi:10.1136/jcp.46.7.672. PMC 501401. PMID 8157759.
- ↑ Dalton R, Chan L, Batten E, Eridani S (October 1986). "Mast cell leukaemia: evidence for bone marrow origin of the pathological clone". Br. J. Haematol. 64 (2): 397–406. doi:10.1111/j.1365-2141.1986.tb04133.x. PMID 3096368. S2CID 9763026.
- ↑ Hoffman R, Benz E, Shattil S, Furie B, Cohen H (2004). Hematology: Basic Principles and Practice (4th ed.). Churchill Livingstone.